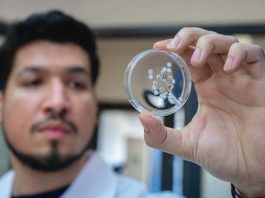
Investigadores crean hidrogel a base de veneno de avispa que cura lesiones de pie diabético

Donación de Órganos: ¿Donarías un órgano?, ¿recibirías uno?
¿Donarías un órgano?, ¿recibirías uno?
¿Eres donante de órganos?, ¿tu familia lo sabe?
¿Donarías tus órganos?, ¿y los de tu hijo o hija?
“Un día puedes ser...
Harvard retira la leche de su guía de alimentación saludable
Asegura que tomar lácteos aumenta el riesgo de padecer cáncer de próstata y cáncer de ovarios
La leche ha sido durante décadas uno de los máximos exponentes...
#BombaDeInsulinaAlAUGE
#BombaDeInsulinaAlAUGE: Campaña para niños Diabéticos
Tras darse a conocer hace algunas semanas que Alonso, el pequeño hijo de Arturo Vidal sufre de diabetes infantil, y...